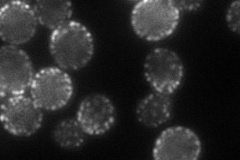
YML052W
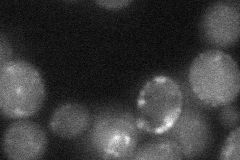
YML052W

View description
Plasma membrane protein that localizes to furrow-like invaginations (MCC patches); component of eisosomes; associated with endocytosis, along with Pil1p and Lsp1p; sporulation and plasma membrane sphingolipid content are altered in mutants
Localization:
Intensity:
Fold change:
Significance:
-
C’ GFP library in SD

below threshold13.99 -
N' NOP1pr-GFP in SD
cell periphery,punctate80.8588 -
N' TEF2pr-mCherry in SD

cell periphery,punctate105.939 -
N' NATIVEpr-GFP in SD

cell periphery,punctate61.2572 -
N' TEF2pr-VC and Cyto-VN in SD
below threshold27.6904 -
C’ GFP library in SD+DTT

cytosol15.251.08No -
C’ GFP library in SD+H2O2

cytosol13.160.94No -
C’ GFP library in Starvation Media

cytosol19.331.38No -
C’ GFP library on the background of Pup2-DaMP

below threshold -
C’ GFP library on the background of CCT mutant

below threshold13.08530.934755No
